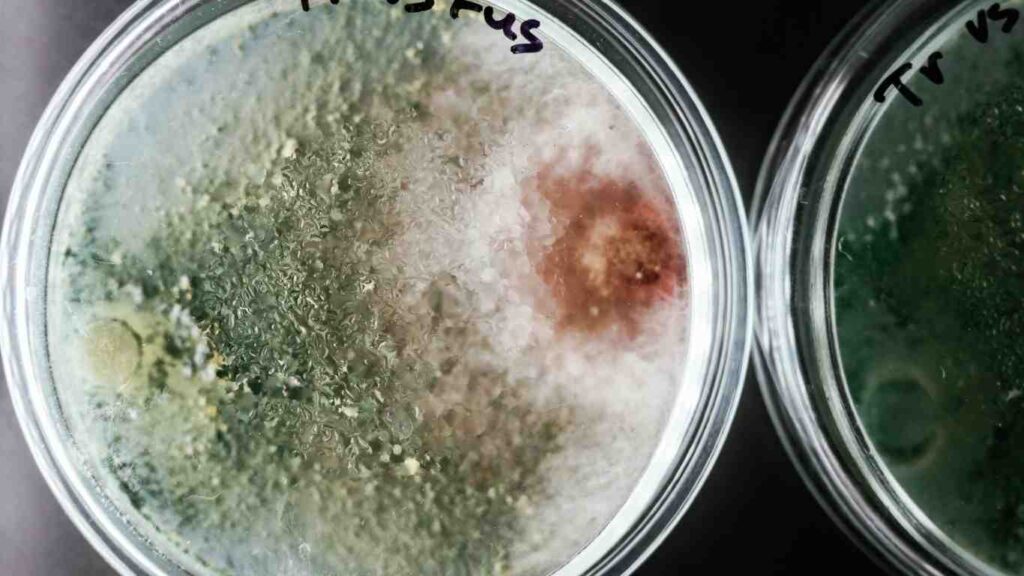
phan-bon-vi-sinh (3)
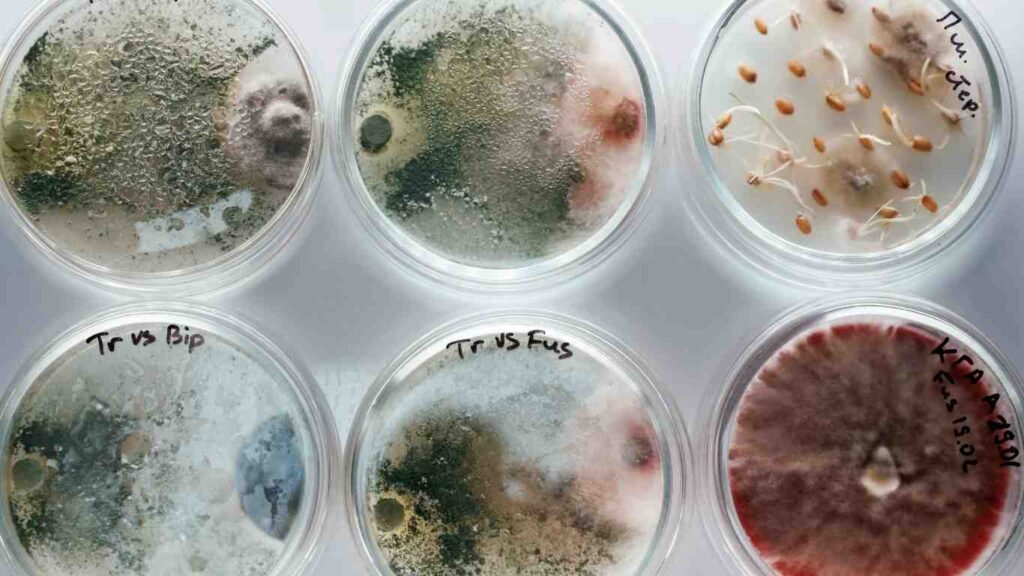
phan-bon-vi-sinh (4)

Phân bón vi sinh đang trở thành xu hướng tất yếu trong canh tác hiện đại, khi người nông dân ngày càng nhận thức rõ tầm quan trọng của việc bảo vệ môi trường đất và sức khỏe cộng đồng. Khác với phân bón hóa học truyền thống chỉ cung cấp dinh dưỡng tức thời, phân bón vi sinh mang đến giải pháp toàn diện – vừa nuôi dưỡng cây trồng, vừa phục hồi và cải tạo đất canh tác từ gốc rễ. Với hàng triệu vi sinh vật có lợi trong mỗi gam sản phẩm, loại phân bón này không chỉ giúp tăng năng suất mà còn giảm thiểu ô nhiễm, tạo nền móng vững chắc cho nền nông nghiệp xanh và bền vững tại Việt Nam.
I. Phân Bón Vi Sinh Là Gì?
Phân bón vi sinh là loại phân bón chứa các vi sinh vật có lợi như vi khuẩn, nấm, xạ khuẩn được nuôi cấy và phát triển trong điều kiện kiểm soát. Các vi sinh vật này khi được bón vào đất sẽ hoạt động giúp cải tạo đất, tăng cường khả năng hấp thu dinh dưỡng cho cây trồng và bảo vệ cây khỏi các tác nhân gây hại. Khác với phân hóa học truyền thống, phân bón vi sinh hoạt động theo cơ chế sinh học tự nhiên, không gây ô nhiễm môi trường và giúp duy trì sự cân bằng sinh thái trong đất.
II. Lợi Ích Vượt Trội Của Phân Bón Vi Sinh

1. Cải Tạo Và Phục Hồi Đất
Phân bón vi sinh giúp phân hủy chất hữu cơ trong đất, chuyển hóa các chất dinh dưỡng khó hòa tan thành dạng dễ hấp thu. Các vi sinh vật có lợi tạo ra các enzyme và acid hữu cơ giúp cải thiện cấu trúc đất, tăng độ xốp và khả năng giữ nước. Điều này đặc biệt quan trọng với những vùng đất bị thoái hóa do sử dụng phân hóa học quá nhiều.
2. Tăng Năng Suất Và Chất Lượng Nông Sản
Nghiên cứu cho thấy sử dụng phân bón vi sinh có thể tăng năng suất từ 20-30% so với chỉ dùng phân hóa học đơn thuần. Các vi sinh vật cố định đạm như Azotobacter và Rhizobium giúp cây hấp thu nitơ từ không khí, giảm 30-40% lượng phân đạm cần bón. Nông sản thu hoạch có hàm lượng dinh dưỡng cao hơn, ít tồn dư hóa chất, đáp ứng tiêu chuẩn xuất khẩu và nông nghiệp hữu cơ.
3. Bảo Vệ Môi Trường Và Phát Triển Bền Vững
Phân bón vi sinh giúp giảm thiểu ô nhiễm nguồn nước do hạn chế việc sử dụng phân hóa học. Vi sinh vật có lợi còn có khả năng phân hủy một số loại thuốc trừ sâu và kim loại nặng trong đất, góp phần làm sạch môi trường canh tác. Đây là giải pháp then chốt để phát triển nông nghiệp bền vững, đáp ứng nhu cầu sản xuất thực phẩm sạch ngày càng cao.
III. Các Loại Phân Bón Vi Sinh Phổ Biến

1. Phân Vi Sinh Cố Định Đạm
Chứa các vi khuẩn như Azotobacter, Azospirillum có khả năng cố định đạm từ không khí. Thích hợp cho hầu hết các loại cây trồng, đặc biệt là lúa, ngô, rau màu. Giúp giảm 30-50% lượng phân đạm hóa học cần bón.
2. Phân Vi Sinh Hòa Tan Lân
Chứa vi khuẩn và nấm có khả năng chuyển hóa lân trong đất từ dạng khó tan thành dạng dễ hấp thu. Đặc biệt hiệu quả trên đất chua, đất có hàm lượng lân tổng cao nhưng khả năng cung cấp thấp. Thích hợp cho cây ăn quả, cây lương thực.
3. Phân Vi Sinh Hòa Tan Kali
Giúp giải phóng kali từ các khoáng vật silicat trong đất. Tăng cường khả năng chống chịu sâu bệnh và điều kiện khắc nghiệt cho cây. Phù hợp với cà phê, tiêu, chè và các cây công nghiệp dài ngày.
4. Phân Vi Sinh Đa Chức Năng
Kết hợp nhiều chủng vi sinh vật khác nhau, mang lại hiệu quả toàn diện: cố định đạm, hòa tan lân kali, kích thích sinh trưởng và bảo vệ cây. Đây là lựa chọn tối ưu cho người trồng mới bắt đầu sử dụng phân vi sinh.
IV. Hướng Dẫn Sử Dụng Phân Bón Vi Sinh Hiệu Quả
1. Thời Điểm Bón
Nên bón phân vi sinh vào buổi chiều mát hoặc tối, tránh ánh nắng mặt trời trực tiếp có thể tiêu diệt vi sinh vật. Thời điểm tốt nhất là khi chuẩn bị đất, trước khi gieo trồng 7-10 ngày và bón thúc giai đoạn cây sinh trưởng mạnh.
2. Liều Lượng Khuyến Cáo
Đối với phân vi sinh dạng lỏng: pha loãng 1:500 đến 1:1000 (1 lít phân pha với 500-1000 lít nước). Phân vi sinh dạng bột: 2-5 kg/ha tùy loại cây và độ phì nhiêu của đất. Luôn đọc kỹ hướng dẫn của nhà sản xuất vì mỗi sản phẩm có nồng độ vi sinh vật khác nhau.
3. Cách Bón Đúng Kỹ Thuật
Bón gốc: Tưới dung dịch phân vi sinh lên luống đất, gần gốc cây. Bón lá: Phun dung dịch loãng lên lá vào buổi chiều mát. Ngâm rễ: Nhúng bộ rễ cây con vào dung dịch phân vi sinh 30-60 phút trước khi trồng. Trộn giá thể: Trộn đều phân vi sinh với đất hoặc giá thể trồng.
4. Lưu Ý Khi Sử Dụng
Không nên trộn phân vi sinh với thuốc trừ sâu, thuốc diệt nấm vì có thể tiêu diệt vi sinh vật có lợi. Bảo quản phân vi sinh ở nơi khô ráo, thoáng mát, tránh ánh nắng trực tiếp. Kiểm tra hạn sử dụng trước khi dùng vì vi sinh vật có thời gian sống hạn chế.
V. Top 5 Sản Phẩm Phân Bón Vi Sinh Được Ưa Chuộng 2025
1. Vi Sinh Vật Hữu Ích EM: Sản phẩm đa chức năng từ Nhật Bản, chứa hơn 80 chủng vi sinh vật. Giá: 150,000-300,000 VNĐ/lít. Thích hợp cho mọi loại cây trồng.
2. Phân Vi Sinh Bão Tàu: Sản phẩm Việt Nam, chuyên dụng cho lúa và cây ngắn ngày. Giá: 80,000-120,000 VNĐ/kg. Hiệu quả cao trong cố định đạm.
3. Vi Sinh Vật Bio Plus: Kết hợp 5 chủng vi khuẩn chính, đặc biệt tốt cho cây ăn trái. Giá: 200,000-350,000 VNĐ/lít. Tăng độ ngọt và hương vị trái.
4. Phân Vi Sinh Trichoderma: Chuyên trị nấm bệnh gây hại, bảo vệ rễ cây. Giá: 100,000-180,000 VNĐ/kg. Hiệu quả với cây trồng trong nhà lưới.

5. Vi Sinh Compost Maker: Chuyên dụng ủ phân compost, tăng tốc độ phân hủy. Giá: 120,000-200,000 VNĐ/kg. Lý tưởng cho người làm phân hữu cơ tại nhà.
VI. Câu Hỏi Thường Gặp (FAQs)
1. Phân bón vi sinh có thay thế hoàn toàn phân hóa học không?
Phân bón vi sinh không thay thế hoàn toàn phân hóa học mà hoạt động bổ trợ, giúp cây hấp thu tốt hơn dinh dưỡng có sẵn trong đất. Bạn có thể giảm 30-50% lượng phân hóa học khi kết hợp với phân vi sinh. Trong nông nghiệp hữu cơ, phân vi sinh kết hợp với phân hữu cơ có thể thay thế hoàn toàn phân hóa học, nhưng cần thời gian để đất thích nghi (6-12 tháng).
2. Bao lâu thì thấy hiệu quả khi sử dụng phân vi sinh?
Hiệu quả ban đầu có thể thấy sau 2-3 tuần sử dụng với dấu hiệu cây xanh tươi, sinh trưởng khỏe hơn. Tuy nhiên, hiệu quả rõ rệt về năng suất thường thấy sau 1-2 vụ canh tác khi hệ vi sinh vật trong đất đã ổn định. Đất càng thoái hóa nặng thì cần thời gian càng lâu để phục hồi (có thể 3-6 tháng).
3. Có nên tự làm phân vi sinh tại nhà không?
Tự làm phân vi sinh tại nhà hoàn toàn khả thi và tiết kiệm chi phí. Bạn có thể làm EM từ cơm nguội, nước vo gạo, đường. Tuy nhiên, chất lượng và nồng độ vi sinh vật không ổn định như sản phẩm công nghiệp. Nếu mới bắt đầu, nên dùng sản phẩm có nguồn gốc rõ ràng để đảm bảo hiệu quả. Sau khi có kinh nghiệm, có thể tự làm để giảm chi phí.
4. Phân vi sinh có hại cho người và vật nuôi không?
Phân bón vi sinh sử dụng vi sinh vật có lợi, an toàn tuyệt đối cho người, vật nuôi và môi trường. Không gây kích ứng da, không độc hại khi hít phải hay nuốt phải. Tuy nhiên, nên rửa tay sau khi sử dụng theo nguyên tắc vệ sinh chung. Sản phẩm chất lượng thường có chứng nhận an toàn từ Bộ Nông nghiệp.
5. Mua phân vi sinh ở đâu uy tín?
Bạn có thể mua phân vi sinh tại: (1) Các cửa hàng vật tư nông nghiệp uy tín trong khu vực, (2) Đại lý phân phối chính thức của các hãng lớn, (3) Sàn thương mại điện tử uy tín như Shopee, Lazada, Tiki – chọn shop có đánh giá tốt và nhiều lượt bán, (4) Trực tiếp từ nhà sản xuất nếu mua số lượng lớn. Lưu ý kiểm tra tem chống giả, hạn sử dụng và bảo quản đúng cách sau khi mua.
6. Có thể dùng phân vi sinh cho cây cảnh trong nhà không?
Hoàn toàn có thể và rất nên dùng phân vi sinh cho cây cảnh. Phân vi sinh giúp cây cảnh khỏe mạnh, lá xanh tươi, ít sâu bệnh mà không gây mùi khó chịu như phân hữu cơ thông thường. Pha loãng nồng độ thấp hơn khuyến cáo (1:1000 đến 1:1500) và tưới 2 lần/tháng. Đặc biệt thích hợp cho cây trong chậu có không gian đất hạn chế.
7. Phân vi sinh có bị mất tác dụng khi bảo quản lâu không?
Phân vi sinh có thời hạn sử dụng thường từ 12-24 tháng kể từ ngày sản xuất. Sau thời gian này, số lượng vi sinh vật sống giảm dần và hiệu quả giảm. Bảo quản đúng cách (nơi khô ráo, thoáng mát, tránh ánh nắng) giúp kéo dài tuổi thọ. Nên mua đúng nhu cầu sử dụng, tránh dự trữ quá nhiều.
8. Có cần ngừng sử dụng phân hóa học ngay khi dùng phân vi sinh?
Không nên ngừng đột ngột hoàn toàn phân hóa học. Hãy giảm dần 30% ở vụ đầu, 50% vụ thứ hai, 70% vụ thứ ba trong khi tăng dần liều lượng phân vi sinh và phân hữu cơ. Cách tiếp cận từ từ này giúp cây và đất thích nghi, tránh sốc dinh dưỡng dẫn đến giảm năng suất. Theo dõi sát sao tình trạng cây để điều chỉnh kịp thời.
VII. Kết Luận
Phân bón vi sinh là giải pháp tối ưu cho nông nghiệp Việt Nam hướng tới sản xuất bền vững và thân thiện môi trường. Với khả năng cải tạo đất, tăng năng suất 20-30% và giảm chi phí phân bón hóa học, đây là lựa chọn thông minh cho mọi loại hình canh tác. Hãy bắt đầu với diện tích nhỏ để thử nghiệm, quan sát kết quả và điều chỉnh phương pháp phù hợp với điều kiện cụ thể của bạn. Đầu tư vào phân bón vi sinh hôm nay chính là đầu tư cho tương lai nông nghiệp xanh và bền vững.
Xem thêm các thông tin khác TẠI ĐÂY
Nếu Quý bà con cần hỗ trợ thêm thông tin kỹ thuật hãy liên hệ cho chúng tôi qua Fanpage hoặc hotline 0901.21.25.26.
Vinasa luôn sẵn sàng hỗ trợ tư vấn kỹ thuật miễn phí cho bà con trong quá trình chăm sóc cây trồng.
Xem thêm bài viết kỹ thuật khác TẠI ĐÂY.
